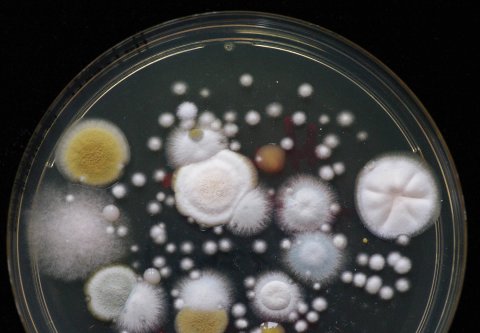

Leistungen
Unsere Leistungen umfassen folgende Punkte:



Ortsbegehung und Probenahme:
Bei der Ortsbegehung wird die Situation vor Ort durch unsere Mitarbeiter erfasst und ein sinnvolles und auf die Fragestellung abgestimmtes Mess- und Analysenprogramm angeboten. Damit wird vermieden, dass unnötige und kostenintensive Messverfahren zur Anwendung kommen. Die bei der Ortsbegehung gewonnenen Eindrücke und Beobachtungen unterstützen die Bewertung der Ergebnisse aus der Probenuntersuchung und versetzen uns in die Lage, gezielte Empfehlungen zur Sanierung zu geben.



Analyse der Proben:
Die ABIS GmbH arbeitet nach anerkannten und wissenschaftlich fundierten Methoden.
Durch die schon seit vielen Jahren erfolgreiche Teilnahme am Ringversuch „Differenzierung von Schimmelpilzen im Innenraum und in Lebensmitteln" (Landesgesundheitsamt Baden-Württemberg) sind die ABIS-Mitarbeiter für die Bestimmung von Schimmelpilzen qualifiziert.
Wir untersuchen als Auftragslabor auch Proben, die vom Kunden selbst genommen und eingeschickt werden. Bitte rufen Sie uns vor dem erstmaligen Einsenden von Proben an, damit wir Ihnen Hinweise zur Probenahme und zum Versand geben können.



Erstellung der Prüfberichte:
Die Ergebnisse erhalten Sie in Form eines Prüfberichts. Darin sind Bewertungshilfen aus der Literatur und aufbauend auf eigener Erfahrung enthalten. Zusätzlich erhalten Sie – in Abhängigkeit der Fragestellung – eine Interpretation und Bewertung der Untersuchungsergebnisse. Empfehlungen zu Sanierungsmaßnahmen können wir vor allem dann geben, wenn wir selbst vor Ort waren.



Beratung:
Wir beraten unsere Kunden zu der jeweiligen Problemstellung und sind gern behilflich bei der Suche nach z. B. Bausachverständigen und Sanierungsfirmen. Die Beratung kann telefonisch oder vor Ort erfolgen.

Vorträge und Schulung:
Im Rahmen von Tagungen oder Informationsveranstaltungen halten wir Vorträge über den Nachweis, die Bewertung und Beseitigung von Innenraumschadstoffen. Die Inhalte der Vorträge können individuell an das Thema der Veranstaltung sowie an das zu erwartende Publikum angepasst werden.
Schulungen können ebenfalls auf den Zweck der Schulung bzw. auf die zu Schulenden abgestimmt werden. Der Umfang einer solchen Veranstaltung kann einige Stunden bis mehrere Tage betragen. Es besteht auch die Möglichkeit, dass wir weitere Vortragende aus anderen Fachbereichen (z. B. Bausachverständige, Sanierungsfirmen, Energieberater) dazu bitten, um ein thematisch abgerundetes Programm anzubieten.
Gerne sprechen wir mit Ihnen die Möglichkeiten durch und unterbreiten Ihnen ein passendes Angebot.
